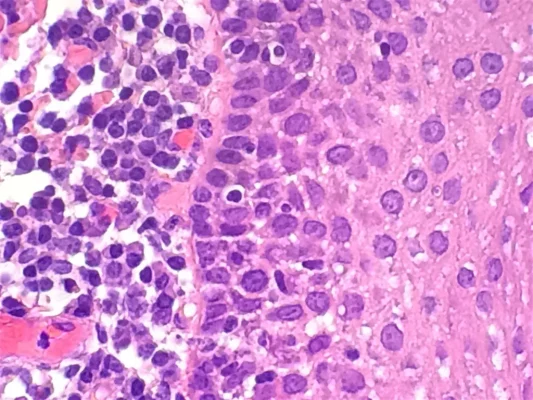

Monthly Archives: March 2024
Stocked and Loaded
At Solmedia we understand the increasing demand of the industry and the pressure laboratories are [...]
27
Mar
Mar
Meet The Team – David Carruth
We asked David some questions to give you an insight into who David is and [...]
19
Mar
Mar
Cromatec – Linear Automatic Slide Stainer
Cromatec is a revolutionary slide Stainer from German engineers and histology equipment specialists SLEE Medical [...]
08
Mar
Mar
What is H&E Staining?
H&E staining, also known as Hematoxylin and Eosin staining, is a commonly used staining technique [...]
05
Mar
Mar